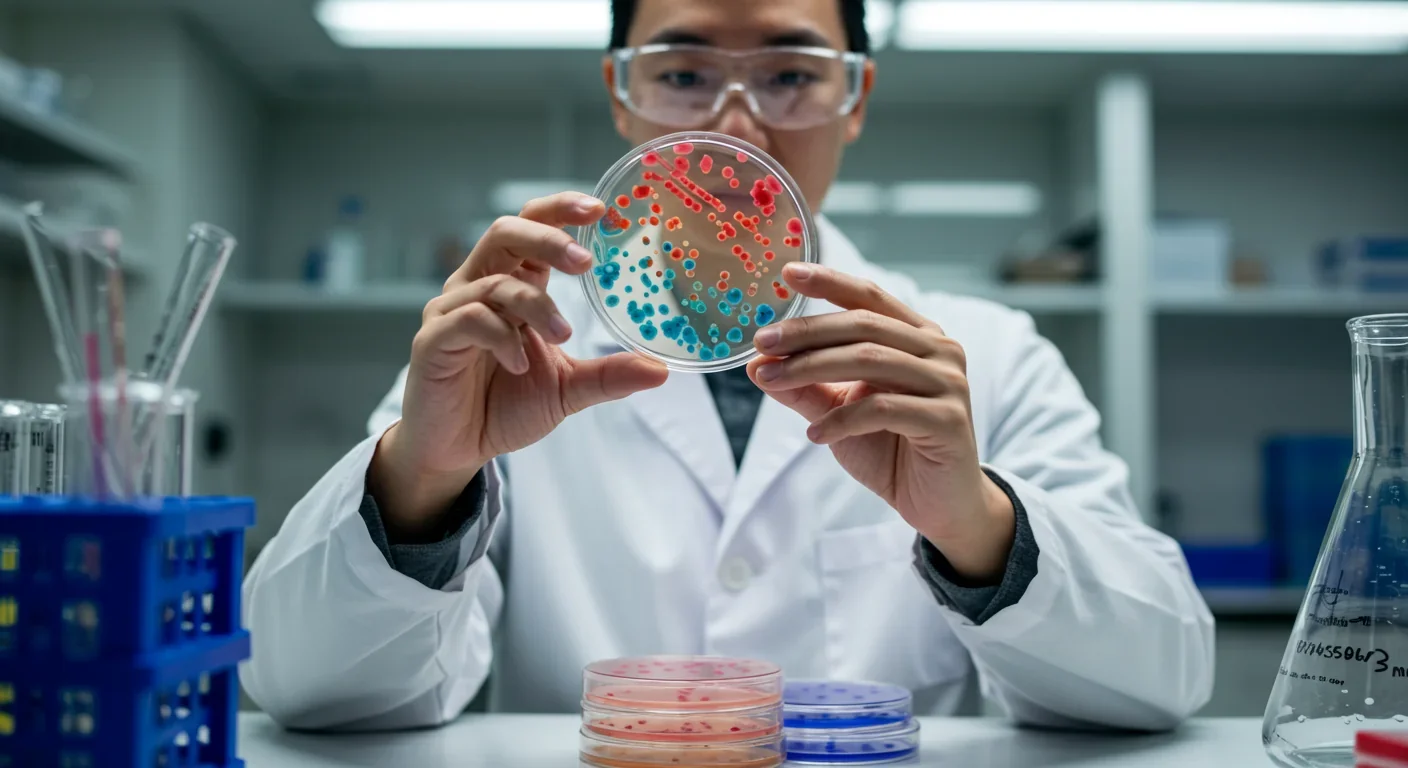
Gut Bacterium Toxin Linked to Colorectal Cancer Risk
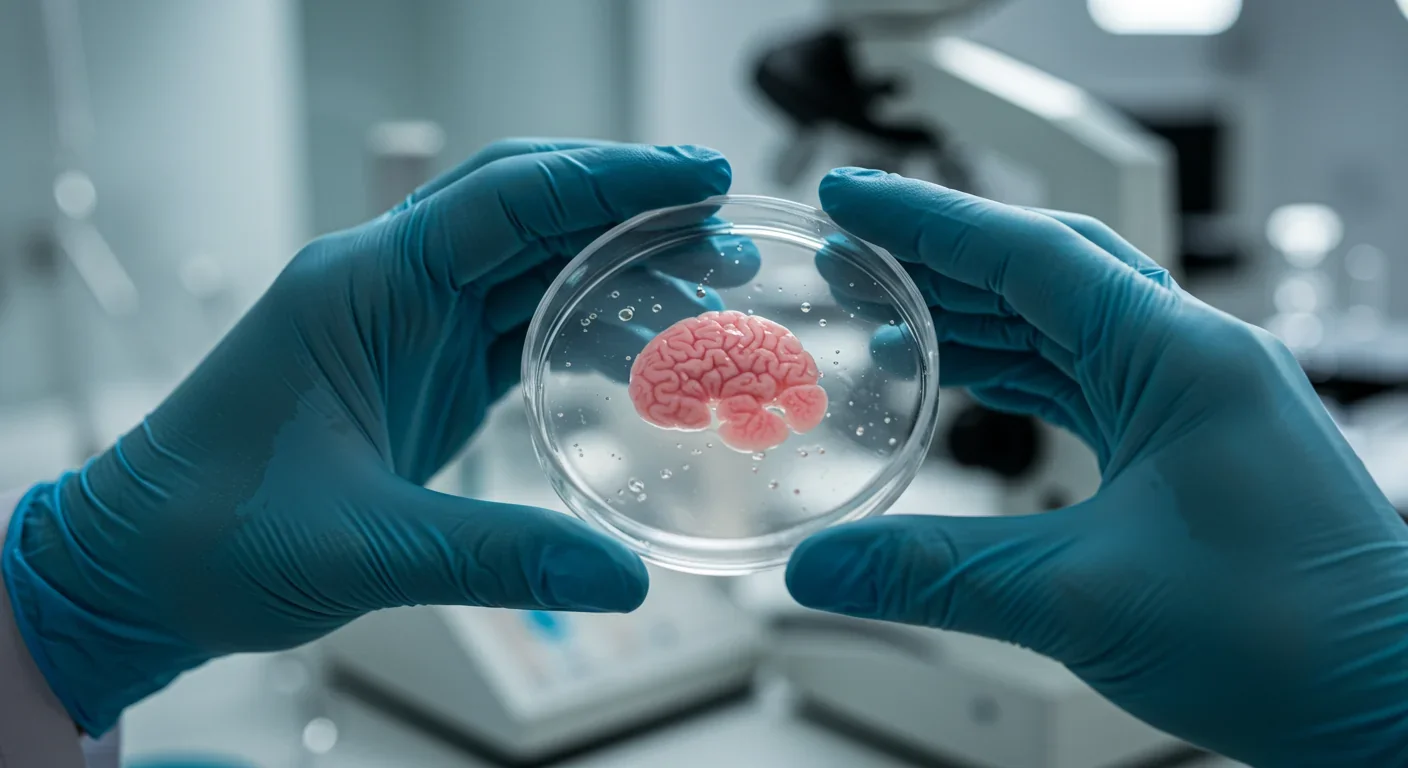
Organoid Intelligence Replaces Animal Testing in Drugs
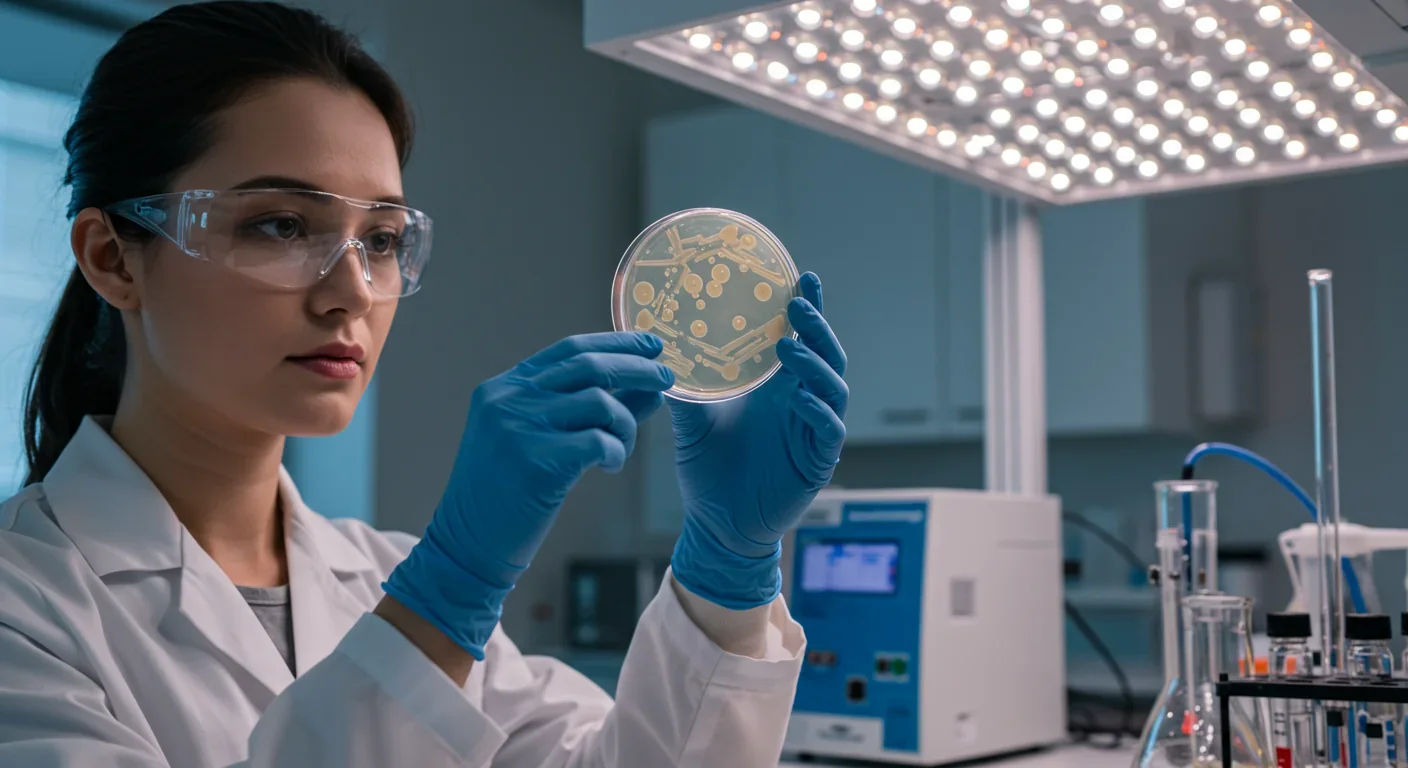
Akkermansia: The Gut Bacterium Fighting Metabolic Disease

Metformin Anti-Aging: How a Diabetes Drug May Slow Aging
Metformin, a cheap diabetes drug taken by 150 million people, may slow aging by mildly stressing cells through mitochondrial complex I inhibition, triggering protective AMPK pathways. The landmark TAME trial is now testing this in humans, potentially making aging itself an FDA-treatable condition.